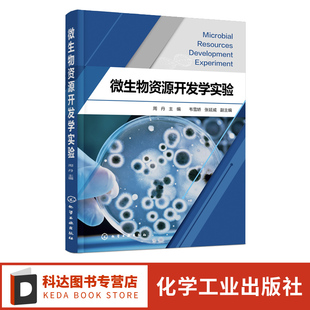

观察方法 细胞组分 分离与分析 医学细胞生物学 线粒体 形态结构 细胞内膜系统与囊泡转运 基本特征 胞生物学概念及研究内容
¥90.598售0件

培养基制备与消毒 无菌操作技术 刘琴 形态观察 大小测定和计数 微生物 夏占峰 著 灭菌 正版 培养方法 微生物学实验指导
¥30.938售0件

培养基制备与消毒 无菌操作技术 刘琴 形态观察 大小测定和计数 微生物 夏占峰 著 灭菌 正版 培养方法 微生物学实验指导
¥30.938售0件

培养基制备与消毒 无菌操作技术 刘琴 形态观察 大小测定和计数 微生物 夏占峰 著 灭菌 正版 培养方法 微生物学实验指导
¥30.938售0件

物种与系统学 9781032114859 从观察到最优系统发生树:形态数据 Observations From 卷 系统发生分析:第 英文原版 现货
¥1048.92满900减30售0件

细菌抗酸性染色法 放线菌形态 观察 微生物学实验 光电比浊计数法 无菌概念和无菌操作技术 微生物接种技术 双向免疫扩散 第四版
¥56.859.8售0件

细菌抗酸性染色法 放线菌形态 观察 微生物学实验 光电比浊计数法 无菌概念和无菌操作技术 微生物接种技术 双向免疫扩散 第四版
¥56.859.8售0件

细菌抗酸性染色法 放线菌形态 观察 微生物学实验 光电比浊计数法 无菌概念和无菌操作技术 微生物接种技术 双向免疫扩散 第四版
¥56.859.8售0件

皮肤 异常 头面望诊 神色形态 舌像 观察人 通过整体望诊 手足望诊 五官九窍等 中医望诊轻松学 络脉 中医入门随手查
¥26.429.8售0件

皮肤 异常 头面望诊 神色形态 舌像 观察人 通过整体望诊 手足望诊 五官九窍等 中医望诊轻松学 络脉 中医入门随手查
¥29.829.8售0件

皮肤 异常 头面望诊 神色形态 舌像 观察人 通过整体望诊 手足望诊 五官九窍等 中医望诊轻松学 络脉 中医入门随手查
¥29.829.8售0件

农业微生物资源开发利用实验 微生物资源开发学实验 微生物形态观察基础实验 应用微生物学课程实验教材 农林环境等专业教材 周丹
¥25.525.5售0件

英语原版 书你可以画系列FantasticAnimals绘画教程绘本适合710岁儿童学习动物形态特征和绘画技巧激发创造力培养观察力和动手能
¥22.9522.95售0件
农业微生物资源开发利用实验 微生物资源开发学实验 微生物形态观察基础实验 应用微生物学课程实验教材 农林环境等专业教材 周丹
¥29.8539.8售0件

细胞基本形态结构观察与显微测量 陈同强 临床口腔麻醉儿科全科医学等专业教师和学生参考教材 医学细胞生物学实验教程 正版
¥2835售0件

细胞基本形态结构观察与显微测量 陈同强 临床口腔麻醉儿科全科医学等专业教师和学生参考教材 医学细胞生物学实验教程 正版
¥2835售0件

观察细胞临时标本片 细胞基本形态 制备细胞 显微等 社 医学细胞生物学与遗传学实验指导第2版 人民卫生出版 马萍等著
¥34.234.2售0件

商务印书馆 自然观察丛书 自然科普读物老鼠博物类书籍 中法图正版 关于老鼠 朱耀沂 老鼠演化形态生理 历史文学童话 老鼠博物学
¥2736售7件

微生物遗传变异与优良菌种 选育与保藏 微生物形态观察 食品微生物学 食品工艺学 朱乐敏 食品加工基础 微生物食品教材书 第二版
¥28.835售2件

化学工业出版 晏成林 社 观察循环过程中 原位X射线反射专业教材书籍 正版 结构和形态演变 原位电化学表征原理方法及应用
¥44.569售1件

微生物遗传变异与优良菌种 选育与保藏 微生物形态观察 食品微生物学 食品工艺学 朱乐敏 食品加工基础 微生物食品教材书 第二版
¥2835售0件

主编 环境微生物学基础实验技术 微生物分离与培养技术 环境微生物学实验技术 建筑工业出版 刘永军 微生物染色与形态观察 陈兴都
¥36.846售0件

社 粉螨防制粉螨显微观察技术 房舍和储藏物粉螨 形态特征生物学生态学 粉螨 昆虫学书籍 科学出版 沈兆鹏主编 李朝品 包邮 正版
¥156.4满88减3售0件

社 粉螨防制粉螨显微观察技术 房舍和储藏物粉螨 形态特征生物学生态学 粉螨 昆虫学书籍 科学出版 沈兆鹏主编 李朝品 包邮 正版
¥156.4满88减3售0件

神经形态学图谱神经科学系统纤维结构功能检查技术结果观察分析指南指导手册化学神经解剖医学染色化学免疫技术参考实用正版 书籍
¥306.5306.5售0件

神经形态学图谱神经科学系统纤维结构功能检查技术结果观察分析指南指导手册化学神经解剖医学染色化学免疫技术参考实用正版 书籍
¥306.5306.5售0件

光学显微标本 制备与观察 科学出版 薛良义 社 细胞骨架 细胞形态观察及显微测量 分离与观察 分子细胞生物学实验指导 叶绿体
¥31.3满20减1售0件

张树剑 东大 由乾針 言古验今:中国针灸思想史论 入侵與獨立 論腧穴 經脈形態――觀察與想像 现货 进口原版
¥101101售0件

21世纪生物学基础课系列实验教材 染色与形态结构观察 微生物学实验注意事项及实验室 微生物 基础性实验 设备 微生物学实验技术
¥47.548售0件

21世纪生物学基础课系列实验教材 染色与形态结构观察 微生物学实验注意事项及实验室 微生物 基础性实验 设备 微生物学实验技术
¥47.548售0件